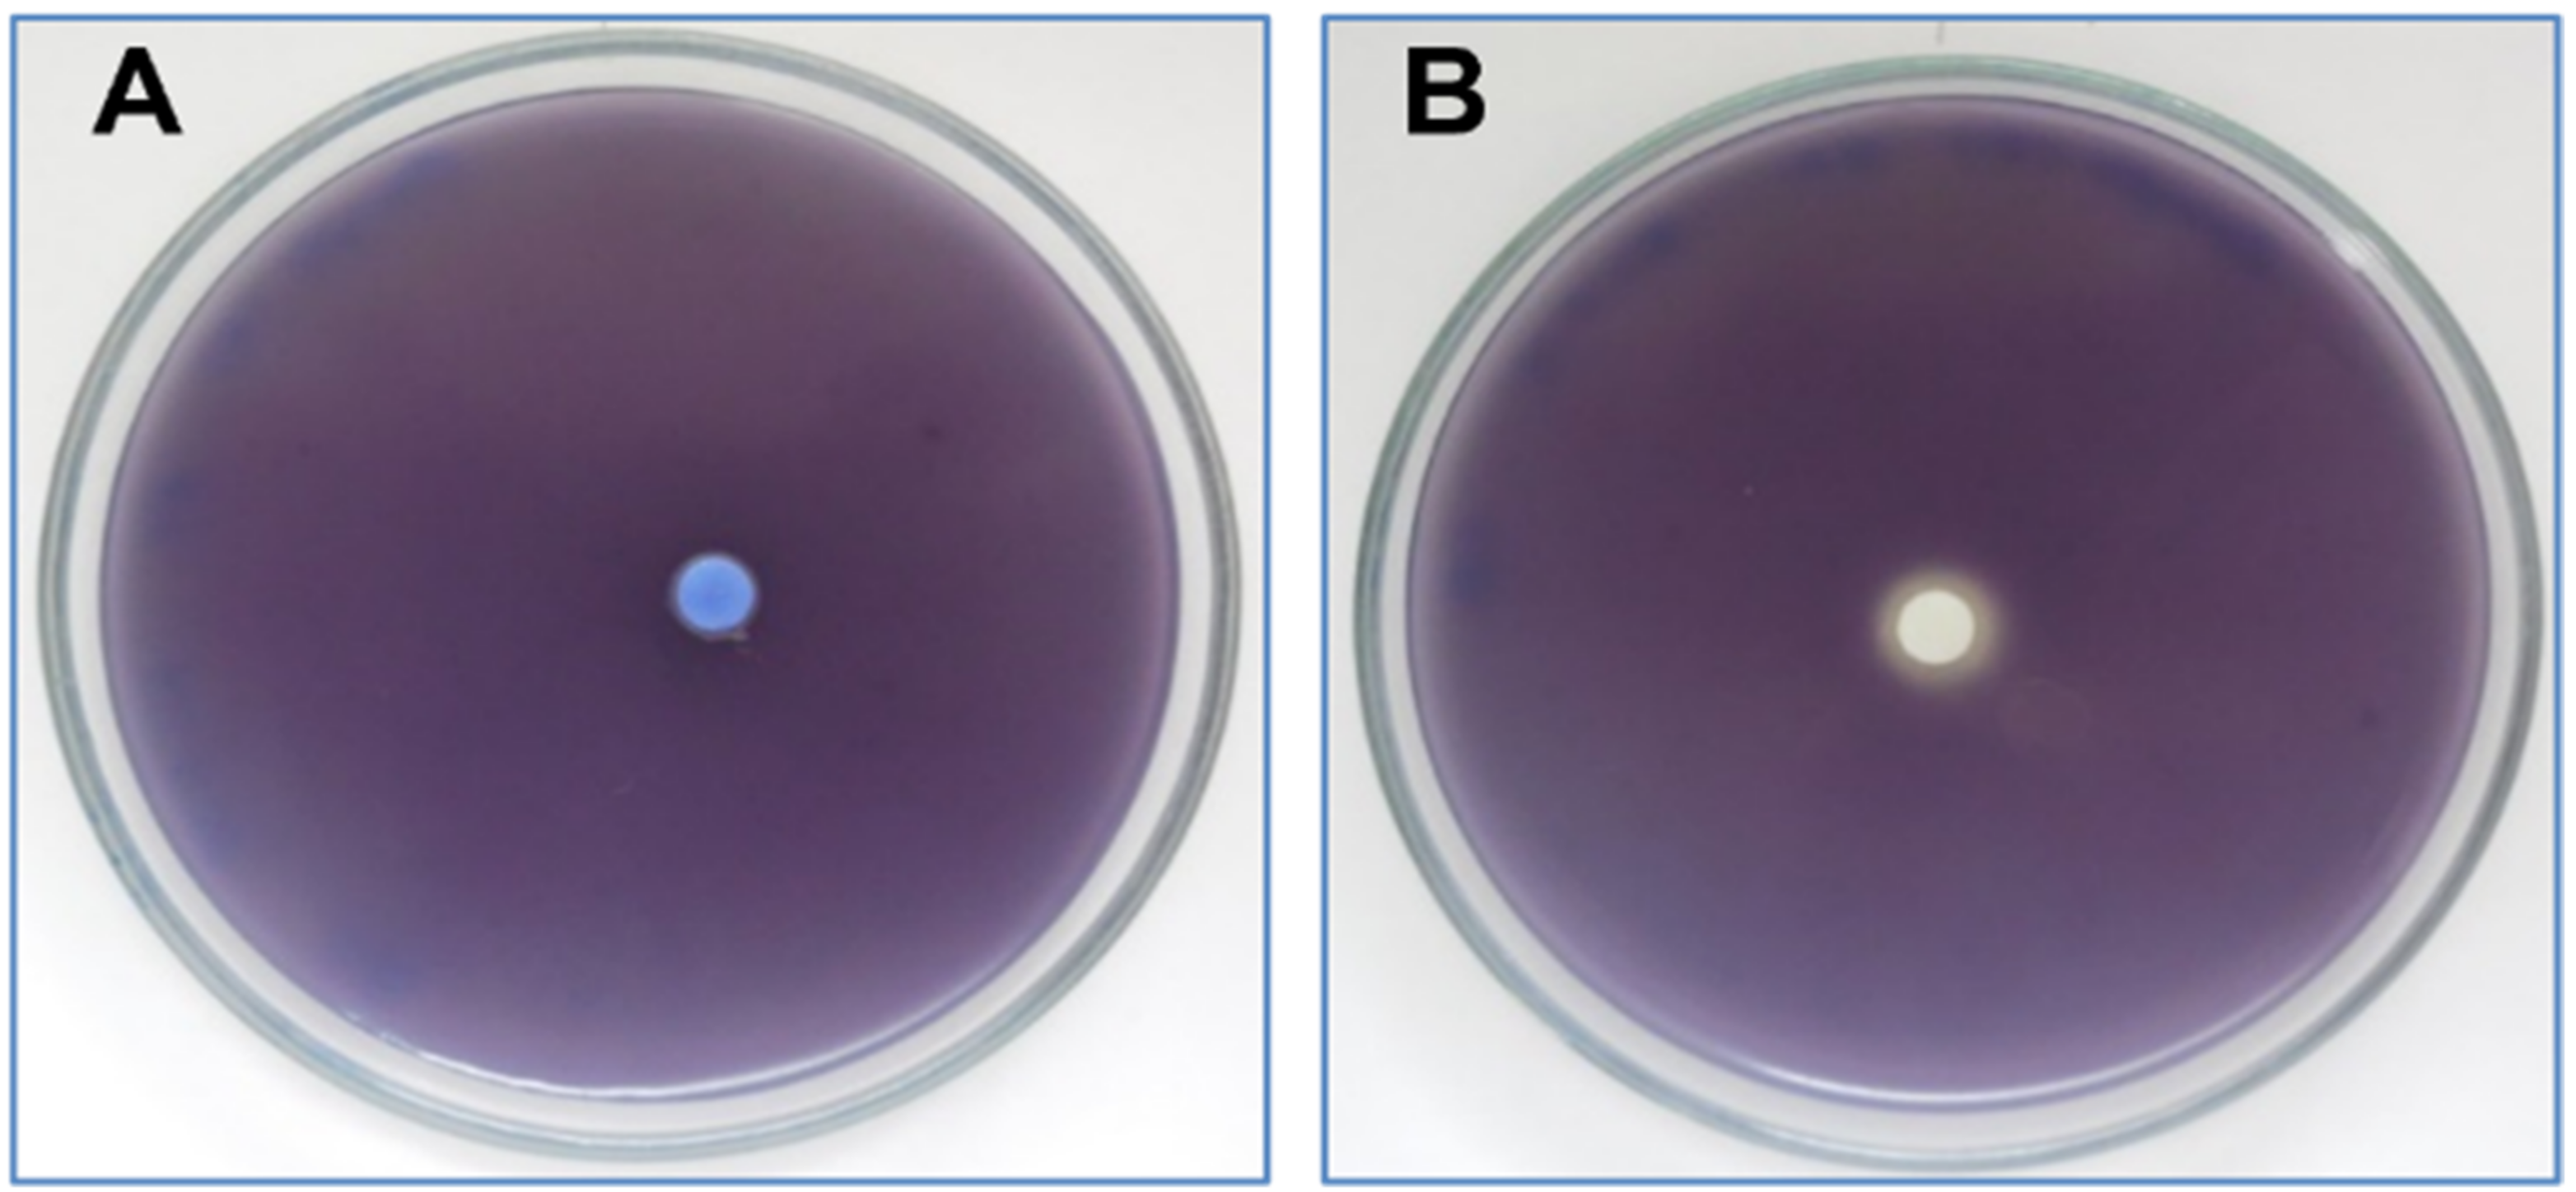
Plants 11 01072 g004

GC-MS Profiling, Vibriocidal, Antioxidant, Antibiofilm, and Anti-Quorum Sensing Properties of Carum carvi L. Essential Oil: In Vitro and In Silico Approaches
Abstract
1. Introduction
2. Results
2.1. Chemical Profile of C. carvi EO
2.2. Antioxidant Activities Screening
2.3. Antimicrobial Activity
2.3.1. Vibriocidal Activities
2.3.2. Biofilm Inhibition and Eradication
2.3.3. Anti-QS Activity
2.4. Molecular Docking Analysis
2.4.1. Molecular Docking Antimicrobial Receptor Proteins
2.4.2. Molecular Docking against Antioxidant Receptor Proteins
2.4.3. Molecular Docking against QS Receptor Proteins
2.5. ADMET Analysis
3. Discussion
4. Materials and Methods
4.1. Plant Material Sampling and Extraction of EO
4.2. Analysis of the Volatile Compounds
4.3. Biological Activities of Caraway Essential Oil
4.3.1. Evaluation of Anti-Vibrio spp. Activities
4.3.2. Evaluation of Antioxidant Activities
4.4. Screening for Anti-Quorum Sensing Activities
4.4.1. Effect on Violacein Production
4.4.2. Effect on QS-Controlled Virulence Factor Production in P. aeruginosa PAO1
4.5. In Silico Approach
4.5.1. Ligand Preparation
4.5.2. Protein Preparation
4.6. ADMET Predicted Properties
4.7. Statistical Analysis
5. Conclusions
Author Contributions
Funding
Institutional Review Board Statement
Informed Consent Statement
Data Availability Statement
Conflicts of Interest
References
- Snoussi, M.; Chaieb, K.; Mahmoud, R.; Bakhrouf, A. Quantitative study, identification and antibiotics sensitivity of some Vibrionaceae associated to a marine fish hatchery. Ann. Microbiol. 2006, 56, 289–293. [Google Scholar] [CrossRef]
- Baker-Austin, C.; Oliver, J.D.; Alam, M.; Ali, A.; Waldor, M.K.; Qadri, F.; Martinez-Urtaza, J. Vibrio spp. infections. Nat. Rev. Dis. Primers 2018, 4, 1–19. [Google Scholar] [CrossRef] [PubMed]
- Dutta, D.; Kaushik, A.; Kumar, D.; Bag, S. Foodborne Pathogenic Vibrios: Antimicrobial Resistance. Front. Microbiol. 2021, 12, 638331. [Google Scholar] [CrossRef] [PubMed]
- Ali, A.; Parisi, A.; Conversano, M.; Iannacci, A.; D’Emilio, F.; Mercurio, V.; Normano, G. Food-Borne Bacteria Associated with Seafoods: A Brief Review. J. Food Qual. Hazards Control 2020, 7, 4–10. [Google Scholar] [CrossRef]
- Dumen, E.; Ekici, G.; Ergin, S.; Bayrakal, G.M. Presence of Foodborne Pathogens in Seafood and Risk Ranking for Pathogens. Foodborne. Pathog. Dis. 2020, 17, 541–546. [Google Scholar] [CrossRef]
- Sheyda, A.; Alexander, D.K.; Marvin, W.; Stephen, P.D. Bacterial Quorum Sensing during Infection. Annu. Rev. Microbiol. 2020, 74, 201–219. [Google Scholar]
- Aye, M.M.; Aung, H.T.; Sein, M.M.; Armijos, C. A Review on the phytochemistry, medicinal properties and pharmacological activities of 15 selected Myanmar medicinal plants. Molecules 2019, 24, 293. [Google Scholar] [CrossRef]
- Felhi, S.; Hajlaoui, H.; Ncir, M.; Bakari, S.; Ktari, N.; Saoudi, M.; Gharsallah, N.; Kadri, A. Nutritional, phytochemical and antioxidant evaluation and FT-IR analysis of freeze-dried extracts of Ecballium elaterium fruit juice from three localities. Food Sci. Technol. 2016, 36, 646–655. [Google Scholar] [CrossRef]
- Felhi, S.; Saoudi, M.; Daoud, A.; Hajlaoui, H.; Ncir, M.; Chaabane, R.; El Feki, A.; Gharsallah, N.; Kadri, A. Investigation of phytochemical contents, in vitro antioxidant and antibacterial behavior and in vivo anti-inflammatory potential of Ecballium elaterium methanol fruits extract. Food Sci. Technol. 2017, 37, 558–563. [Google Scholar] [CrossRef]
- Bakari, S.; Daoud, A.; Felhi, S.; Smaoui, S.; Gharsallah, N.; Kadri, A. Proximate analysis, mineral composition, phytochemical contents antioxidant and antimicrobial activities and GC-MS investigation of various solvent extracts of Cactus cladode. Food Sci. Technol. 2017, 27, 286–293. [Google Scholar] [CrossRef]
- Bakari, S.; Hajlaoui, H.; Daoud, A.; Mighri, H.; Ross-Garcia, J.M.; Gharsallah, N.; Kadri, A. Phytochemicals, antioxidant and antimicrobial potentials and LC-MS analysis of hydroalcoholic extracts of leaves and flowers of Erodium glaucophyllum collected from Tunisian Sahara. Food Sci. Technol. 2018, 38, 310–317. [Google Scholar] [CrossRef]
- Hajlaoui, H.; Mighri, H.; Aouni, M.; Gharsallah, N.; Kadri, A. Chemical composition and in vitro evaluation of antioxidant antimicrobial, cytotoxicity and anti-acetylcholinesterase properties of Tunisian Origanum majorana L. essential oil. Microb. Pathog. 2016, 95, 86–94. [Google Scholar] [CrossRef]
- Hajlaoui, H.; Arraouadi, S.; Noumi, E.; Aouadi, K.; Adnan, M.; Khan, M.A.; Kadri, A.; Snoussi, M. antimicrobial, antioxidant, anti-acetylcholinesterase, antidiabetic, and pharmacokinetic properties of Carum carvi L. and Coriandrum sativum L. essential oils alone and in combination. Molecules 2021, 26, 3625. [Google Scholar] [CrossRef]
- Daoud, A.; Ben Mefteh, F.; Mnafgui, K.; Turki, M.; Jmal, S.; Ben Amar, R.; Ayadi, F.; ElFeki, A.; Abid, L.; Rateb, M.E.; et al. Cardiopreventive effect of ethanolic extract of date palm pollen against isoproterenol induced myocardial infarction in rats through the inhibition of the angiotensin-converting enzyme. Exp. Toxicol. Pathol. 2017, 69, 656–665. [Google Scholar] [CrossRef]
- Ben Mefteh, F.; Daoud, A.; Chenari Bouket, A.; Thissera, B.; Kadri, Y.; Cherif-Silini, H.; Eshelli, M.; Alenezi, F.N.; Vallat, A.; Oszako, T.; et al. Date palm trees root-derived endophytes as fungal cell factories for diverse bioactive metabolites. Int. J. Mol. Sci. 2018, 19, 1986. [Google Scholar] [CrossRef]
- Bakari, S.; Ncir, M.; Felhi, S.; Hajlaoui, H.; Saoudi, M.; Gharsallah, N.; Kadri, A. Chemical composition and in vitro evaluation of total phenolic, flavonoid, and antioxidant properties of essential oil and solvent extract from the aerial parts of Teucrium polium grown in Tunisia. Food Sci. Biotechnol. 2015, 24, 1943–1949. [Google Scholar] [CrossRef]
- Baig, B.; Abdel Halim, S.; Farrukh, A.; Greish, Y.; Amin, A. Current status of nanomaterial-based treatment for hepatocellular carcinoma. Biomed. Pharmacother. 2019, 116, 108852. [Google Scholar] [CrossRef]
- Benassi, E.; Fan, K.; Sun, Q.; Dukenbayev, K.; Wang, Q.; Shaimoldina, A.; Tassanbiyeva, A.; Nurtay, L.; Nurkesh, A.; Kutzhanova, A.; et al. Generation of particle assemblies mimicking enzymatic activity by processing of herbal food: The case of rhizoma polygonati and other natural ingredients in traditional Chinese medicine. Nanoscale Adv. 2021, 3, 2222. [Google Scholar] [CrossRef]
- Xie, Y.; Mu, C.; Kazybay, B.; Sun, Q.; Kutzhanova, A.; Nazarbek, G.; Xu, N.; Nurtay, L.; Wang, Q.; Amin, A.; et al. Network pharmacology and experimental investigation of Rhizoma polygonati extract targeted kinase with herbzyme activity for potent drug delivery. Drug Deliv. 2021, 28, 2187–2197. [Google Scholar] [CrossRef]
- El-Kharrag, R.; Amin, A.; Hisaindee, S.; Greish, Y.; Karam, S.M. Development of a therapeutic model of precancerous liver using crocin-coated magnetite nanoparticles. Int. J. Oncol. 2017, 50, 212–222. [Google Scholar] [CrossRef]
- Kadri, A.; Zarai, Z.; Chobba, I.B.; Gharsallah, N.; Damak, M.; Békir, A. Chemical composition and in vitro antioxidant activities of Thymelaea hirsuta L: Essential oil from Tunisia. Afr. J. Biotechnol. 2011, 10, 2930–2935. [Google Scholar]
- Mseddi, K.; Alimi, F.; Noumi, E.; Veettil, V.N.; Deshpande, S.; Adnan, M.; Hamdi, A.; Elkahoui, S.; Alghamdi, A.; Kadri, A.; et al. Thymus musilii Velen. as a promising source of potent bioactive compounds with its pharmacological properties: In vitro and in silico analysis. Arab. J. Chem. 2020, 13, 6782–6801. [Google Scholar] [CrossRef]
- Goyal, M.; Gupta, V.K.; Singh, N.; Mrinal. Carum carvi— An Updated Review. Indian J. Pharm. Biol. Res. 2018, 6, 14–24. [Google Scholar]
- Rasooli, I.; Allameh, A. Caraway (Carum carvi L.) essential oils. In Essential Oils in Food Preservation, Flavor and Safety; Preedy, V.R., Ed.; Academic Press: San Diego, CA, USA, 2016; Chapter 32; pp. 287–293. [Google Scholar]
- Dadkhah, A.; Allameh, A.; Khalafi, H.; Ashrafihelan, J. Inhibitory effects of dietary caraway essential oils on 1,2-dimethylhydrazine-induced colon carcinogenesis is mediated by liver xenobiotic metabolizing enzymes. Nutr. Cancer 2010, 63, 46–54. [Google Scholar] [CrossRef]
- European Pharmacopoeia, 7th ed.; Council of Europe: Strasbourg, France, 2010; Volume 1.
- Raal, A.; Arak, E.; Orav, A. The content and composition of the essential oil found in Carum carvi L. commercial fruits obtained from different countries. J. Essent. Oil Res. 2012, 24, 53–59. [Google Scholar] [CrossRef]
- Snoussi, M.; Hajlaoui, H.; Noumi, E.; Usai, D.; Sechi, L.A.; Zanetti, S.; Bakhrouf, A. In-vitro anti-Vibrio spp. activity and chemical composition of some Tunisian aromatic plants. World J. Microbiol. Biotechnol. 2008, 24, 3071–3076. [Google Scholar] [CrossRef]
- Snoussi, M.; Noumi, E.; Dehmani, A.; Flamini, G.; Aouni, M.; Alsieni, M.; Al-sieni, A. Chemical composition and antimicrobial activities of Elettaria cardamomum L. (Manton) essential oil: A high activity against a wide range of food borne and medically important bacteria and fungi. J. Chem. Biol. Phys. Sci. 2015, 6, 248–259. [Google Scholar]
- Snoussi, M.; Dehmeni, A.; Noumi, E.; Flamini, G.; Papetti, A. Chemical composition and Antibiofilm activity of Petroselinum crispum and Ocimum basilicum essential oils against Vibrio spp. strains. Microb. Pathog. 2016, 90, 13–21. [Google Scholar] [CrossRef]
- Snoussi, M.; Trabelsi, N.; Dehmeni, A.; Benzekri, R.; Bouslama, L.; Hajlaoui, B.; Al-sieni, A.; Papetti, A. Phytochemical analysis, antimicrobial and antioxidant activities of Allium roseum var. odoratissimum (Desf.) Coss extracts. Ind. Crops Products 2016, 89, 533–542. [Google Scholar] [CrossRef]
- Gracia-Valenzuela, M.H.; Vergara-Jiménez, M.J.; Baez-Flores, M.E.; Cabrera-Chavez, F. Antimicrobial effect of dietary oregano essential oil against vibrio bacteria in shrimps. Arch. Biol. Sci. 2014, 66, 1367–1370. [Google Scholar] [CrossRef]
- Partovi, R.; Khanjari, A.; Abbaszadeh, S.; Sharifzadeh, A. Chemical composition and antimicrobial effect of five essential oils on pathogenic and non -pathogenic Vibrio parahaemolyticus. Nut. Food Sci. Res. 2017, 4, 43–52. [Google Scholar] [CrossRef]
- Porto, C.; Stüker, C.Z.; Mallmann, A.S.; Simionatto, E.; Flach, A.; Canto-Dorow, T.; Silva, U.F.; Dalcol, I.I.; Morel, A.F. (R)-(−)-carvone and (1R, 4R)-trans-(+)-dihydrocarvone from Poiretia latifolia vogel. J. Braz. Chem. Soc. 2010, 21, 782–786. [Google Scholar] [CrossRef]
- Snoussi, M.; Noumi, E.; Trabelsi, N.; Flamini, G.; Papetti, A.; De Feo, V. Mentha spicata essential oil: Chemical composition, antioxidant and antibacterial activities against planktonic and biofilm cultures of Vibrio spp. strains. Molecules 2015, 20, 14402–14424. [Google Scholar] [CrossRef]
- Mizan, M.F.R.; Ashrafudoulla, M.; Hossain, M.I.; Cho, H.R.; Ha, S.D. Effect of essential oils on pathogenic and biofilm-forming Vibrio parahaemolyticus strains. Biofouling 2020, 36, 467–478. [Google Scholar] [CrossRef]
- Mendes, J.L.; de Araújo, T.F.; Geraldo de Carvalho, M.; Catunda, A.; Júnior, F.E. Chemical composition and mechanism of vibriocidal action of essential oil from resin of Protium heptaphyllum. Sci. J. 2019, 2019, 9563213. [Google Scholar] [CrossRef][Green Version]
- Nazzaro, F.; Fratianni, F.; De Martino, L.; Coppola, R.; De Feo, V. Effect of essential oils on pathogenic bacteria. Pharmaceuticals 2013, 6, 1451–1474. [Google Scholar] [CrossRef]
- Bai, A.J.; Vittal, R.R. Quorum sensing inhibitory and anti-biofilm activity of essential oils and their in vivo efficacy in food systems. Food Biotechnol. 2014, 28, 269–292. [Google Scholar] [CrossRef]
- Noumi, E.; Merghni, A.; Alreshidi,, M.M.; Haddad, O.; Akmadar, G.; De Martino, L.; Mastouri, M.; Ceylan, O.; Snoussi, M.; Al-sieni, A.; et al. Chromobacterium violaceum and Pseudomonas aeruginosa PAO1: Models for evaluating anti-quorum sensing activity of Melaleuca alternifolia essential oil and its main component terpinen-4-ol. Molecules 2018, 23, 2672. [Google Scholar]
- Camele, I.; Elshafie, H.S.; Caputo, L.; De Feo, V. Anti-quorum sensing and antimicrobial effect of Mediterranean plant essential oils against phytopathogenic bacteria. Front. Microbiol. 2019, 10, 2619. [Google Scholar] [CrossRef]
- Snoussi, M.; Noumi, E.; Punchappady-Devasya, R.; Trabelsi, N.; Kanekar, S. Antioxidant properties and anti-quorum sensing potential of Carum copticum essential oil and phenolics against Chromobacterium violaceum. J. Food Sci. Technol. 2018, 55, 2824–2832. [Google Scholar] [CrossRef]
- Cáceres, M.; Hidalgo, W.; Stashenko, E.; Torres, R.; Ortiz, C. Essential oils of aromatic plants with antibacterial, anti-biofilm and anti-quorum sensing activities against pathogenic bacteria. Antibiotics 2020, 9, 147. [Google Scholar] [CrossRef] [PubMed]
- Alreshidi, M.; Noumi, E.; Bouslama, L.; Ceylan, O.; Veettil, V.N.; Adnan, M.; Danciu, C.; Elkahoui, S.; Badraoui, R.; Al-Motair, K.A.; et al. Phytochemical screening, antibacterial, antifungal, antiviral, cytotoxic, and anti-quorum-sensing properties of Teucrium polium L. aerial parts methanolic extract. Plants 2020, 9, 1418. [Google Scholar] [CrossRef] [PubMed]
- Vasavi, H.S.; Arun, A.B.; Rekha, P.D. Anti-quorum sensing potential of Adenanthera pavonina. Pharmacogn. Res. 2015, 7, 105–109. [Google Scholar]
- Kanekar, S.; Fathima, F.; Rekha, P.D. Carvone—A quorum sensing inhibitor blocks biofilm formation in Chromobacterium violaceum. Nat. Prod. Res. 2021, 1–6. [Google Scholar] [CrossRef]
- Luciardi, M.C.; Blázquez, M.A.; Alberto, M.R.; Cartagena, E.; Arena, M.E. Grapefruit essential oils inhibit quorum sensing of Pseudomonas aeruginosa. Food Sci. Technol. Int. 2020, 26, 231–241. [Google Scholar] [CrossRef]
- Luciardi, M.C.; Blázquez, M.A.; Alberto, M.R.; Cartagena, E.; Arena, M.E. Lemon oils attenuate the pathogenicity of Pseudomonas aeruginosa by quorum sensing inhibition. Molecules 2021, 26, 2863. [Google Scholar] [CrossRef]
- Nazzaro, F.; Fratianni, F.; Coppola, R.; Feo, V. Essential Oils and Antifungal Activity. Pharmaceuticals 2017, 10, 86. [Google Scholar] [CrossRef]
- Alminderej, F.; Bakari, S.; Almundarij, T.I.; Snoussi, M.; Aouadi, K.; Kadri, A. Antioxidant activities of a new chemotype of Piper cubeba L. fruit essential oil (Methyleugenol/Eugenol): In Silico molecular docking and ADMET studies. Plants 2020, 9, 1534. [Google Scholar] [CrossRef]
- Aouadi, K.; Hajlaoui, H.; Arraouadi, S.; Ghannay, S.; Snoussi, M.; Kadri, A. HPLC/MS phytochemical profiling with antioxidant activities of Echium humile Desf. extracts: ADMET prediction and computational study targeting human peroxiredoxin 5 receptor. Agronomy 2021, 11, 2165. [Google Scholar] [CrossRef]
- Noumi, E.; Snoussi, M.; Anouar, E.H.; Alreshidi, M.; Veettil, V.N.; Elkahoui, S.; Adnan, M.; Patel, M.; Kadri, A.; Aouadi, K.; et al. HR-LCMS-Based Metabolite Profiling, Antioxidant, and Anticancer Properties of Teucrium polium L. Methanolic Extract: Computational and In Vitro Study. Antioxidants 2020, 9, 1089. [Google Scholar] [CrossRef]
- Othman, I.M.M.; Gad-Elkareem, M.A.M.; Anouar, E.H.; Aouadi, K.; Snoussi, M.; Kadri, A. New substituted pyrazolones and dipyrazolotriazines as promising tyrosyl-tRNA synthetase and peroxiredoxin-5 inhibitors: Design, synthesis, molecular docking and structure-activity relationship (SAR) analysis. Bioorg. Chem. 2021, 109, 104704. [Google Scholar] [CrossRef]
- De Clercq, E.; Naesens, L.; De Bolle, L.; Schols, D.; Zhang, Y.; Neyts, J. Antiviral agents active against human herpesviruses HHV-6, HHV-7 and HHV-8. Rev. Med. Virol. 2001, 11, 381–395. [Google Scholar] [CrossRef]
- Alminderej, F.; Bakari, S.; Almundarij, T.I.; Snoussi, M.; Aouadi, K.; Kadri, A. Antimicrobial and wound healing potential of a new chemotype from Piper cubeba L. essential oil and in silico study on S. aureus tyrosyl-tRNA synthetase protein. Plants 2021, 10, 205. [Google Scholar] [CrossRef]
- Othman, I.M.M.; Gad-Elkareem, M.A.M.; Anouar, E.H.; Snoussi, M.; Aouadi, K.; Kadri, A. Novel fused pyridine derivatives containing pyrimidine moiety as prospective tyrosyl-tRNA synthetase inhibitors: Design, synthesis, pharmacokinetics and molecular docking studies. J. Mol. Struct. 2020, 1219, 128651. [Google Scholar] [CrossRef]
- Eswaramoorthy, R.; Hailekiros, H.; Kedir, F.; Endale, M. In silico molecular docking, dft analysis and admet studies of carbazole alkaloid and coumarins from roots of Clausena anisata: A potent inhibitor for quorum sensing. Adv. Appl. Bioinform. Chem. 2021, 5, 13–24. [Google Scholar] [CrossRef]
- Wang, M.; Zhao, L.; Wu, H.; Zhao, C.; Gong, Q.; Yu, W. Cladodionen Is a Potential Quorum Sensing Inhibitor Against Pseudomonas aeruginosa. Mar. Drugs 2020, 18, 205. [Google Scholar] [CrossRef]
- Hajlaoui, H.; Snoussi, M.; Ben Jannet, H.; Elmighri, Z.; Bakhrouf, A. Chemical composition and antimicrobial activities of Tunisian essential oil of Mentha longifolia L. ssp. used in the folkloric medicine. Ann. Microbiol. 2008, 58, 513–520. [Google Scholar] [CrossRef]
- Ben Salha, G.; Herrera Díaz, R.; Lengliz, O.; Abderrabba, M.; Labidi, J. Effect of the chemical composition of free-terpene hydrocarbons essential oils on antifungal activity. Molecules 2019, 24, 3532. [Google Scholar] [CrossRef]
- Koleva, I.I.; van Beek, T.A.; Linssen, J.P.; de Groot, A.; Evstatieva, L.N. Screening of plant extracts for antioxidant activity: A comparative study on three testing methods. Phytochem. Anal. 2002, 13, 8–17. [Google Scholar] [CrossRef]
- Hajlaoui, H.; Mighri, H.; Noumi, E.; Snoussi, M.; Trabelsi, N.; Ksouri, R.; Bakhrouf, A. Chemical composition and biological activities of Tunisian Cuminum cyminum L. essential oil: A high effectiveness against Vibrio spp. strains. Food Chem. Toxicol. 2010, 48, 2186–2192. [Google Scholar] [CrossRef]
- Oyaizu, M. Studies on product of browning reaction prepared from glucose amine. Jpn. J. Nut. 1986, 44, 307. [Google Scholar] [CrossRef]
- Noumi, E.; Snoussi, M.; Alreshidi, M.M.; Rekha, P.D.; Saptami, K.; Caputo, L.; De Martino, L.; Souza, L.F.; Msaada, K.; Mancini, E.; et al. Chemical and biological evaluation of essential oils from Cardamom species. Molecules 2018, 23, 2818. [Google Scholar] [CrossRef] [PubMed]
- Kim, S.; Chen, J.; Cheng, T.; Gindulyte, A.; He, J.; He, S.; Li, Q.; Shoemaker, B.A.; Thiessen, P.A.; Yu, B.; et al. PubChem in 2021: New data content and improved web interfaces. Nucleic Acids Res. 2021, 49, D1388–D1395. [Google Scholar] [CrossRef] [PubMed]
- Hanwell, M.D.; Curtis, D.E.; Lonie, D.C.; Vandermeersch, T.; Zurek, E.; Hutchison, G.R. Avogadro: An advanced semantic chemical editor, visualization, and analysis platform. J. Cheminform. 2012, 4, 17. [Google Scholar] [CrossRef]
- Tasleem, M.; Ishrat, R.; Islam, A.; Ahmad, F.; Hassan, I. Structural Characterization, Homology Modeling and Docking Studies of ARG674 Mutation in MyH8 Gene Associated with Trismus-Pseudocamptodactyly Syndrome. Lett. Drug Des. Discov. 2014, 11, 1177–1187. [Google Scholar] [CrossRef]
- Trott, O.; Olson, A.J. AutoDock Vina: Improving the speed and accuracy of docking with a new scoring function, efficient optimization, and multithreading. J. Comput. Chem. 2010, 31, 455–461. [Google Scholar] [CrossRef]
- Azam, S.S.; Abbasi, S.W. Molecular docking studies for the identification of novel melatoninergic inhibitors for acetylserotonin-O-methyltransferase using different docking routines. Theor Biol Med. Model. 2013, 10, 63. [Google Scholar] [CrossRef]

| Code | Components | l.r.i. | Percentage | MW (g·mol−1) | Chemical Formula |
|---|---|---|---|---|---|
| Monoterpene hydrocarbons (39%) | |||||
| 1 | Myrcene | 993 | 0.4 | 136.238 | C10H16 |
| 2 | D-3-carene | 1013 | 0.1 | 136.238 | C10H16 |
| 3 | Limonene | 1032 | 38.5 | 136.238 | C10H16 |
| Oxygenated monoterpenes (59.6%) | |||||
| 4 | trans-p-mentha-2.8-dien-1-ol | 1126 | 0.1 | 152.237 | C10H16O |
| 5 | cis-limonene oxide | 1136 | 0.1 | 152.230 | C10H16O |
| 6 | cis-p-mentha-2.8-dien-1-ol | 1139 | 0.1 | 152.230 | C10H16O |
| 7 | cis-dihydrocarvone | 1195 | 0.7 | 152.230 | C10H16O |
| 8 | trans-dihydrocarvone | 1202 | 0.2 | 152.230 | C10H16O |
| 9 | trans-carveol | 1219 | 0.1 | 152.230 | C10H16O |
| 10 | cis-carveol | 1231 | 0.1 | 152.230 | C10H16O |
| 11 | Carvone | 1242 | 58.2 | 150.220 | C10H14O |
| Phenylpropanoids (0.1%) | |||||
| 12 | Eugenol | 1358 | 0.1 | 164.200 | C10H12O2 |
| DPPH IC50 (mg/mL) | Reducing Power EC50 (mg/mL) | β-Carotene IC50 (mg/mL) | Chelating Power IC50 (mg/mL) | |
|---|---|---|---|---|
| C. carvi EO | 15 ± 0.23 a | 7.8 ± 0.01 c | 3.9 ± 0.025 a | 6.8 ± 0.05 b |
| Ascorbic acid | 12 ± 0.01 b | 25 ± 0.01 a | - | - |
| BHT | 11.5 ± 0.62 b | 23.00 ± 1.0 b | 4.60 ± 1.60 a | - |
| EDTA | - | - | - | 32.50 ± 1.32 a |
| Microorganisms Tested | Disc Diffusion Assay | Microdilution Assay | |||||||
|---|---|---|---|---|---|---|---|---|---|
| (GIZ ± SD) | C | AM | E | TE | G | MIC | MBC | MBC/MIC Ratio | |
| V. cholerae ATCC 9459 | 23.33 ± 0.58 l | 27 | 8 | 6 | 20 | 18 | 0.022 | 5.781 | >4; Bacteriostatic |
| V. cholerae | 11.67 ± 0.58 cd | 8 | 10 | 6 | 21 | 20 | 0.022 | 5.781 | >4; Bacteriostatic |
| V. vulnificus ATCC 27962 | 30.33 ± 0.58 n | 17 | 7 | 26 | 24 | 16 | 0.022 | 23.125 | >4; Bacteriostatic |
| V. vulnificus S5 | 11.33 ± 0.58 c | 18 | 7 | 17 | 13 | 19 | 0.022 | 5.781 | >4; Bacteriostatic |
| V. vulnificus V30 | 13.33 ± 0.58 e | 30 | 6 | 6 | 25 | 20 | 0.022 | 11.562 | >4; Bacteriostatic |
| V. parahaemolyticus ATCC 17802 | 16.00 ± 0.00 g | 8 | 7 | 7 | 17 | 17 | 0.022 | 11.562 | >4; Bacteriostatic |
| V. parahaemolyticus ATCC 43996 | 22.66 ± 0.58 l | 22 | 7 | 14 | 17 | 18 | 0.022 | 2.890 | >4; Bacteriostatic |
| V. parahaemolyticus I12 | 16.66 ± 0.58 gh | 7 | 7 | 14 | 20 | 16 | 0.022 | 11.562 | >4; Bacteriostatic |
| V. parahaemolyticus I22 | 25.33 ± 0.58 m | 19 | 10 | 14 | 15 | 20 | 0.022 | 11.562 | >4; Bacteriostatic |
| V. parahaemolyticus | 12.66 ± 0.58 de | 24 | 7 | 12 | 14 | 18 | 0.022 | 5.781 | >4; Bacteriostatic |
| V. parahaemolyticus S949 | 11.33 ± 0.58 fg | 13 | 7 | 7 | 13 | 20 | 0.022 | 5.781 | >4; Bacteriostatic |
| V. parahaemolyticus S950 | 11.67 ± 0.58 cd | 13 | 10 | 7 | 15 | 17 | 0.022 | 11.562 | >4; Bacteriostatic |
| V. alginolyticus ATCC 33787 | 17.66 ± 0.58 h | 22 | 6 | 22 | 17 | 17 | 0.022 | 11.562 | >4; Bacteriostatic |
| V. alginolyticus ATCC 17749 | 37.33 ± 0.58 o | 25 | 7 | 7 | 16 | 12 | 0.045 | 2.890 | >4; Bacteriostatic |
| V. alginolyticus | 24.66 ± 0.58 m | 20 | 6 | 20 | 15 | 10 | 0.022 | 11.562 | >4; Bacteriostatic |
| V. alginolyticus S6 | 11.67 ± 0.58 cd | 13 | 6 | 7 | 11 | 12 | 0.022 | 2.890 | >4; Bacteriostatic |
| V. alginolyticus S7 | 12.67 ± 0.58 de | 29 | 15 | 14 | 7 | 23 | 0.090 | 23.125 | >4; Bacteriostatic |
| V. alginolyticus S5 | 22.66 ± 0.58 l | 18 | 8 | 15 | 13 | 20 | 0.022 | 2.891 | >4; Bacteriostatic |
| V. furnisii ATCC 35016 | 8.66 ± 0.58 a | 33 | 7 | 30 | 20 | 13 | 0.022 | 23.125 | >4; Bacteriostatic |
| V. cincinnatiensis ATCC 35912 | 10.33 ± 058 b | 24 | 7 | 30 | 18 | 15 | 0.022 | 23.125 | >4; Bacteriostatic |
| V. proteolyticus ATCC 15338 | 20.33 ± 0.58 j | 24 | 8 | 10 | 16 | 16 | 0.022 | 11.562 | >4; Bacteriostatic |
| V. natrigens ATCC 14048 | 21.67 ± 0.58 k | 18 | 13 | 25 | 16 | 14 | 0.022 | 5.781 | >4; Bacteriostatic |
| V. mimicus ATCC 33653 | 21.33 ± 0.58 k | 18 | 10 | 12 | 15 | 14 | 0.022 | 11.562 | >4; Bacteriostatic |
| V. fluvialis ATCC 33809 | 14.66 ± 0.58 f | 11 | 7 | 7 | 17 | 18 | 0.022 | 11.562 | >4; Bacteriostatic |
| V. anguillarum | 23.66 ± 0.58 l | 24 | 6 | 19 | 14 | 20 | 0.045 | 5.781 | >4; Bacteriostatic |
| V. carhiaccae ATCC 35084 | 14.33 ± 0.58 f | 6 | 10 | 7 | 15 | 17 | 0.022 | 5.781 | >4; Bacteriostatic |
| V. harveyi ATCC 18293 | 17.66 ± 0.58 h | 27 | 7 | 12 | 16 | 20 | 0.022 | 5.781 | >4; Bacteriostatic |
| V. diazotrophicus ATCC 33466 | 12.00 ± 0.00 cd | 22 | 8 | 30 | 19 | 18 | 0.022 | 11.562 | >4; Bacteriostatic |
| V. tapetis CECT 4600T | 20.00 ± 1.00 ij | 10 | 19 | 6 | 34 | 15 | 0.022 | 11.562 | >4; Bacteriostatic |
| V. splendidus ATCC 33125 | 19.33 ± 0.58 i | 22 | 6 | 22 | 24 | 16 | 0.022 | 11.562 | >4; Bacteriostatic |
| A. hydrophila ATCC 7966T | 16.66 ± 0.58 gh | 23 | 8 | 7 | 19 | 15 | 0.022 | 11.562 | >4; Bacteriostatic |
| Control (PAO1 Strain) | Concentrations Tested (mg/mL) | |||||
|---|---|---|---|---|---|---|
| 2.5 | 1.25 | 0.625 | 0.5 | 0.05 | ||
| C. carviEO | 54.00 ± 0.00 | 11.33 ± 0.57 | 13.33 ± 0.57 | 15.66 ± 0.57 | 16.00 ± 0.00 | 17.33 ± 1.15 |
| Carvone | 54.00 ± 0.00 | 11.00 ± 0.00 | 11.66 ± 0.57 | 13.00 ± 0.00 | 14.33 ± 0.57 | 15.66 ± 0.57 |
| Concentration Tested | % of Violacein Inhibition |
|---|---|
| MIC; (10 mg/mL) | 47.57 ± 3.7 a |
| MIC/2; (5 mg/mL) | 32.26 ± 2.2 b |
| MIC/4; (2.5 mg/mL) | 29.17 ± 1.3 b |
| MIC/8; (1.25 mg/mL) | 28.21 ± 6.1 b |
| MIC/16; (0.625 mg/mL) | 27.89 ± 6.0 b |
| MIC/32; (0.312 mg/mL) | 25.28 ± 4.3 b |
| Compounds | Interacting Residues Receptor vs. Targets | Binding Energy (kcal/mol) |
|---|---|---|
| trans-p-mentha-2.8-dien-1-ol vs. 1HD2 | van der Waals: Thr147. Alkyl/Pi-Alkyl: Pro40 (4.13), Pro45 (5.04), Phe120 (5.20). | −5.2 |
| trans-dihydrocarvone vs. IJIJ | van der Waals: Ala39. C-H bond: Cys37(3.06), Gly38 (2.50), Alkyl/Pi-Alkyl: Tyr36 (4.33), Cys37 (4.49). | −6.3 |
| trans-carveol vs. 1JIJ | Alkyl/Pi-Alkyl: Cys37 (), Ala39 (), Tyr36 (). | −6.4 |
| Eugenol vs. IJIJ | van der Waals: Tyr36. H bond: Asp40 (2.50), Thr75 (1.95), Tyr170 (2.88). C-H bond: Gln196 (2.52). Alkyl/Pi-Alkyl: Cys37(4.50), Leu70 (5.40). | −6.3 |
| cis-carveol vs. 2XCT | C-H bond: Leu1348; Alkyl/Pi-Alkyl: Ala1351, Ile1346, Leu1168, Met1335, Leu1348, Leu1167, Ile1183, Ile1346, Val1038, Tyr1234. | −5.3 |
| Carvone vs. 2XCT | H bond: Ala1337 (2.55), Ile1346 (2.12). C-H bond: Ile1336, Leu1345. Alkyl: Val1038, Ala1337, Met1335, Ile1346, Leu1168, Val1339, Leu1167. | −5.3 |
| Limonene vs. 2UV0 | van der Waals: Val76, Alkyl/Pi-Alkyl: Tyr93 (5.50), Tyr56 (5.08) (5.38), Tyr64 (3.98) (4.98), Leu36 (4.82), Leu110 (3.07) (5.26) (5.42), Trp88 (3.96) (4.75). | −7.4 |
| trans-carveol vs. 2UV0 | Alkyl/Pi-Alkyl: Cys79 (5.17), Tyr47 (5.45), Val76 4.39, Leu40 (4.20), Leu125 (3.65) (3.93), Tyr64 (4.93). | −7.5 |
| Carvone vs. 3IX3 | H bond: Arg61 (2.71). Alkyl/Pi-Alkyl: Leu36 (4.67) (5.27), Tyr56 (4.94), Tyr64 (4.33) (4.76), Trp88 (5.74) (5.86). P-Lone Pair: Tyr64 (2.71) | −7.5 |
| trans-dihydrocarvone vs. 3IX3 | van der Waals: Tyr56. H bond: Trp60 (2.65), Alkyl/Pi-Alkyl: Leu36 (4.75), Tyr64 (4.56), Trp88 (4.56) (5.71), Leu110 (4.38). | −7.5 |
| Limonene vs. 3QP1 | van der Waals: Trp111, Alkyl/Pi-Alkyl: Ile99 (4.42), Tyr80 (4.61), Leu57 (4.23), Leu85 (4.26), Met89 (5.21), Tyr88 (3.74) (5.21). | −7.4 |
| Carvone vs. 3QP1 | H bond: Trp84 (3.21). Pi-Sigma: Trp111 (3.53). Alkyl/Pi-Alkyl: Leu100 (5.05), Tyr80 (4.98), Leu57 (4.29) (4.49), Leu85 (5.17), Tyr88 (4.16), Ile99 (4.37) (4.68), Phe115 (5.23), Trp111(5.37). | −7.5 |
| ADMET Predicted Profile | 1 | 2 | 3 | 4 | ||||
|---|---|---|---|---|---|---|---|---|
| Results | Probability | Results | Probability | Results | Probability | Results | Probability | |
| Absorption | ||||||||
| Human Intestinal Absorption | + | 0.9698 | + | 0.9819 | + | 0.9692 | + | 0.9795 |
| Caco-2 Permeability | + | 0.7783 | + | 0.7793 | + | 0.7994 | + | 0.6792 |
| Blood–Brain Barrier | + | 0.9967 | + | 0.9911 | + | 0.9962 | + | 0.9564 |
| Human oral bioavailability | - | 0.5286 | + | 0.8000 | + | 0.6143 | - | 0.6286 |
| Subcellular localization | Nucleus | 0.5972 | Lysosomes | 0.7499 | Lysosomes | 0.6471 | Lysosomes | 0.5661 |
| P-glycoprotein inhibitor | - | 0.9810 | - | 0.9663 | - | 0.9834 | - | 0.9846 |
| P-glycoprotein substrate | - | 0.9692 | - | 0.9250 | - | 0.9317 | - | 0.8969 |
| Distribution and Metabolism | ||||||||
| CYP3A4 substrate | - | 0.6665 | - | 0.5787 | - | 0.6282 | - | 0.5108 |
| CYP2C9 substrate | - | 0.8209 | - | 0.7890 | - | 0.8110 | - | 0.7759 |
| CYP2D6 substrate | - | 0.7550 | - | 0.7441 | - | 0.7415 | - | 0.7764 |
| CYP3A4 inhibition | - | 0.9747 | - | 0.8365 | - | 0.9257 | - | 0.7643 |
| CYP2C9 inhibition | - | 0.9178 | - | 0.7654 | - | 0.9308 | - | 0.8692 |
| CYP2C19 inhibition | - | 0.8849 | - | 0.7419 | - | 0.8906 | - | 0.8058 |
| CYP2D6 inhibition | - | 0.9341 | - | 0.9171 | - | 0.9398 | - | 0.9189 |
| CYP1A2 inhibition | - | 0.7790 | - | 0.7877 | - | 0.7497 | - | 0.8169 |
| CYP inhibitory promiscuity | - | 0.7215 | - | 0.7928 | - | 0.7657 | - | 0.9195 |
| Excretion and Toxicity | ||||||||
| Carcinogenicity | + | 0.5429 | - | 0.7571 | - | 0.4589 | - | 0.7857 |
| Ames mutagenesis | - | 0.9200 | - | 0.8700 | - | 1.0000 | - | 0.8600 |
| Human ether-a-go-go inhibition | - | 0.6620 | - | 0.4935 | - | 0.5586 | - | 0.5665 |
| Micronuclear | - | 0.9900 | - | 0.9200 | - | 1.0000 | - | 0.9700 |
| Hepatotoxicity | - | 0.8250 | - | 0.8250 | - | 0.8250 | - | 0.8000 |
| Acute Oral Toxicity | III | 0.8030 | III | 0.8186 | III | 0.9069 | III | 0.8083 |
| Biodegradation | + | 0.9000 | + | 0.5500 | + | 0.9500 | + | 0.8000 |
| ADMET Predicted Profile (Regression) | ||||||||
| Water solubility | −3.443 | −4.227 | −3.937 | −1.609 | ||||
| Plasma protein binding | 0.433 | 0.837 | 0.373 | 0.555 | ||||
| Acute Oral Toxicity | 1.66 | 1.5 | 1.856 | 3.839 | ||||
| Tetrahymena pyriformis | 1.193 | 0.252 | 0.113 | −0.445 | ||||
| ADMET Predicted Profile | 5 | 6 | 7 | 8 | ||||
| Results | Probability | Results | Probability | Results | Probability | Results | Probability | |
| Absorption | ||||||||
| Human Intestinal Absorption | + | 0.9840 | + | 0.9795 | + | 0.9873 | + | 0.9873 |
| Caco-2 Permeability | + | 0.7132 | + | 0.6792 | + | 0.7226 | + | 0.7226 |
| Blood–Brain Barrier | + | 0.9743 | + | 0.9564 | + | 0.9778 | + | 0.9778 |
| Human oral bioavailability | + | 0.7000 | - | 0.6286 | + | 0.6286 | + | 0.6286 |
| Subcellular localization | Lysosomes | 0.5804 | Lysosomes | 0.5661 | Mitochondria | 0.5743 | Mitochondria | 0.5743 |
| P-glycoprotein inhibitor | - | 0.9840 | - | 0.9846 | - | 0.9772 | - | 0.9772 |
| P-glycoprotein substrate | - | 0.9223 | - | 0.8969 | - | 0.9097 | - | 0.9097 |
| Distribution and Metabolism | ||||||||
| CYP3A4 substrate | + | 0.5411 | - | 0.5108 | - | 0.6066 | - | 0.6066 |
| CYP2C9 substrate | - | 1.0000 | - | 0.7759 | - | 0.8012 | - | 0.8012 |
| CYP2D6 substrate | - | 0.7083 | - | 0.7764 | - | 0.7855 | - | 0.7855 |
| CYP3A4 inhibition | - | 0.8418 | - | 0.7643 | - | 0.9166 | - | 0.9166 |
| CYP2C9 inhibition | - | 0.5512 | - | 0.8692 | - | 0.9518 | - | 0.9518 |
| CYP2C19 inhibition | + | 0.5571 | - | 0.8058 | - | 0.8753 | - | 0.8753 |
| CYP2D6 inhibition | - | 0.9316 | - | 0.9189 | - | 0.9395 | - | 0.9395 |
| CYP1A2 inhibition | + | 0.7089 | - | 0.8169 | - | 0.7044 | - | 0.7044 |
| CYP inhibitory promiscuity | - | 0.8628 | - | 0.9195 | - | 0.8829 | - | 0.8829 |
| Excretion and Toxicity | ||||||||
| Carcinogenicity | - | 0.8857 | - | 0.7857 | - | 0.7857 | - | 0.7857 |
| Ames mutagenesis | - | 0.9000 | - | 0.8600 | - | 0.8200 | - | 0.8200 |
| Human ether-a-go-go inhibition | - | 0.5581 | - | 0.5665 | - | 0.7524 | - | 0.7524 |
| Micronuclear | - | 0.8100 | - | 0.9700 | - | 1.0000 | - | 1.0000 |
| Hepatotoxicity | - | 0.7500 | - | 0.8000 | - | 0.8500 | - | 0.8500 |
| Acute Oral Toxicity | III | 0.8102 | III | 0.8083 | III | 0.8245 | III | 0.8245 |
| Biodegradation | + | 0.6000 | + | 0.8000 | + | 0.8500 | + | 0.8500 |
| ADMET Predicted Profile (Regression) | ||||||||
| Water solubility | −2.724 | −1.609 | −2.117 | −2.117 | ||||
| Plasma protein binding | 0.589 | 0.555 | 0.394 | 0.394 | ||||
| Acute Oral Toxicity | 1.438 | 3.839 | 2.061 | 2.061 | ||||
| Tetrahymena pyriformis | 0.762 | −0.445 | 0.236 | 0.236 | ||||
| ADMET Predicted Profile | 9 | 10 | 11 | 12 | ||||
| Results | Probability | Results | Probability | Results | Probability | Results | Probability | |
| Absorption | ||||||||
| Human Intestinal Absorption | + | 0.9859 | + | 0.9859 | + | 0.9956 | + | 0.9767 |
| Caco-2 Permeability | + | 0.7041 | + | 0.7041 | + | 0.7047 | + | 0.6118 |
| Blood–Brain Barrier | + | 0.9406 | + | 0.9406 | + | 0.9791 | + | 0.9260 |
| Human oral bioavailability | + | 0.5714 | + | 0.5714 | + | 0.5714 | - | 0.5857 |
| Subcellular localization | Mitochondria | 0.4869 | Mitochondria | 0.4869 | Mitochondria | 0.6420 | Mitochondria | 0.7362 |
| P-glycoprotein inhibitor | - | 0.9772 | - | 0.9772 | - | 0.9716 | - | 0.9765 |
| P-glycoprotein substrate | - | 0.8702 | - | 0.8702 | - | 0.9360 | - | 0.8741 |
| Distribution and Metabolism | ||||||||
| CYP3A4 substrate | - | 0.6433 | - | 0.6433 | - | 0.6171 | + | 0.5312 |
| CYP2C9 substrate | - | 0.8090 | - | 0.8090 | - | 0.8078 | - | 1.0000 |
| CYP2D6 substrate | - | 0.7021 | - | 0.7021 | - | 0.8631 | - | 0.6817 |
| CYP3A4 inhibition | - | 0.8309 | - | 0.8309 | - | 0.8964 | - | 0.9404 |
| CYP2C9 inhibition | - | 0.9206 | - | 0.9206 | - | 0.9425 | - | 0.9581 |
| CYP2C19 inhibition | - | 0.7038 | - | 0.7038 | - | 0.6994 | - | 0.8321 |
| CYP2D6 inhibition | - | 0.8987 | - | 0.8987 | - | 0.9069 | - | 0.9267 |
| CYP1A2 inhibition | - | 0.8306 | - | 0.8306 | - | 0.8146 | - | 0.8382 |
| CYP inhibitory promiscuity | - | 0.8346 | - | 0.8346 | - | 0.8246 | - | 0.9270 |
| Excretion and Toxicity | ||||||||
| Carcinogenicity | - | 0.8571 | - | 0.8571 | - | 0.6768 | - | 0.8429 |
| Ames mutagenesis | - | 0.9500 | - | 0.9500 | - | 0.9600 | - | 0.6300 |
| Human ether-a-go-go inhibition | - | 0.5592 | - | 0.5592 | - | 0.5429 | - | 0.5685 |
| Micronuclear | - | 0.8900 | - | 0.8900 | - | 0.8100 | - | 0.9700 |
| Hepatotoxicity | - | 0.8000 | - | 0.8000 | - | 0.6750 | - | 0.8750 |
| Acute Oral Toxicity | III | 0.8021 | III | 0.8021 | III | 0.8144 | III | 0.7376 |
| Biodegradation | + | 0.7750 | + | 0.7750 | + | 0.6500 | - | 0.5250 |
| ADMET Predicted Profile (Regression) | ||||||||
| Water solubility | −2.258 | −2.258 | −1.998 | −2.874 | ||||
| Plasma protein binding | 0.546 | 0.546 | 0.654 | 0.895 | ||||
| Acute Oral Toxicity | 1.896 | 1.896 | 1.845 | 3.394 | ||||
| Tetrahymena pyriformis | 0.162 | 0.162 | 0.6 | 0.012 | ||||
| Protein (PDB ID) | Grid Size (x, y, z Points) | Grid Dimension Center (x, y, z Coordinates) | Grid Spacing in Å |
|---|---|---|---|
| 1HD2 | 40 × 40 × 40 | 7.089, 41.659, 34.385 | 0.375 |
| 1JIJ | 40 × 40 × 40 | −11.273, 13.817, 86.080 | 0.375 |
| 2UV0 | 40 × 40 × 40 | 23.998, 16.050, 80.315 | 0.375 |
| 2XCT | 52 × 52 × 52 | 30.098, 32.836, 89.243 | 0.375 |
| 3IX3 | 52 × 52 × 52 | 14.630, −1.973, 9.690 | 0.375 |
| 3QP1 | 38 × 40 × 40 | 20.546, 12.912, 49.410 | 0.375 |
| 3QPR | 126 × 126 × 126 | 54.057, 84.102, 205.034 | 0.375 |
| 3HIR | 60 × 60 × 60 | −26.388, 13.803, −15.845 | 0.375 |
Publisher’s Note: MDPI stays neutral with regard to jurisdictional claims in published maps and institutional affiliations. |
© 2022 by the authors. Licensee MDPI, Basel, Switzerland. This article is an open access article distributed under the terms and conditions of the Creative Commons Attribution (CC BY) license (https://creativecommons.org/licenses/by/4.0/).
Share and Cite
Ghannay, S.; Aouadi, K.; Kadri, A.; Snoussi, M. GC-MS Profiling, Vibriocidal, Antioxidant, Antibiofilm, and Anti-Quorum Sensing Properties of Carum carvi L. Essential Oil: In Vitro and In Silico Approaches. Plants 2022, 11, 1072. https://doi.org/10.3390/plants11081072
Ghannay S, Aouadi K, Kadri A, Snoussi M. GC-MS Profiling, Vibriocidal, Antioxidant, Antibiofilm, and Anti-Quorum Sensing Properties of Carum carvi L. Essential Oil: In Vitro and In Silico Approaches. Plants. 2022; 11(8):1072. https://doi.org/10.3390/plants11081072
Chicago/Turabian StyleGhannay, Siwar, Kaïss Aouadi, Adel Kadri, and Mejdi Snoussi. 2022. "GC-MS Profiling, Vibriocidal, Antioxidant, Antibiofilm, and Anti-Quorum Sensing Properties of Carum carvi L. Essential Oil: In Vitro and In Silico Approaches" Plants 11, no. 8: 1072. https://doi.org/10.3390/plants11081072
APA StyleGhannay, S., Aouadi, K., Kadri, A., & Snoussi, M. (2022). GC-MS Profiling, Vibriocidal, Antioxidant, Antibiofilm, and Anti-Quorum Sensing Properties of Carum carvi L. Essential Oil: In Vitro and In Silico Approaches. Plants, 11(8), 1072. https://doi.org/10.3390/plants11081072

